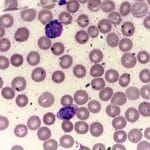
Leishman's Stain

Leishman’s Stain
Showing the single result
-
Leishman’s Stain
Kinyoun’s carbol fuchsin staining solution for acid-fast bacteria.
It is generally used to differentiate between and identify white blood cells, malaria parasites, and trypanosomas.
Ref: D26086
Read MoreSelect options This product has multiple variants. The options may be chosen on the product page